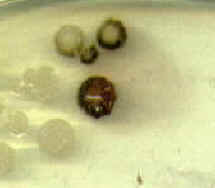

Tour of Microbes  Tour Home | Disease Home | Microbes A to Z | Bio 203 Home |
Neisseria gonorrhoea
cells
Neisseria colonies
Oxidase-positive reaction of Neisseria
Neisseria is a Gram-negative diplococcus responsible for such serious diseases as gonorrhea and meningitis. Neisserias are obligate aerobes, oxidase-positive, and fastidious. Many can survive inside of host white blood cells, and infections are often identified by finding Gram-negative diplococci in a stain.
Domain Bacteria
Phylum Proteobacteria
Class β -Proteobacteria
Bergey's Manual Volume 2: The Proteobacteria